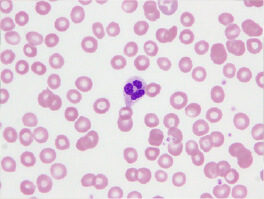
形態的検査3
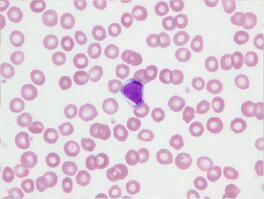
形態的検査4
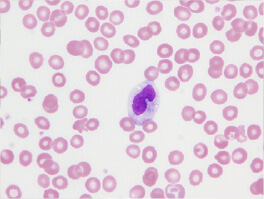
形態的検査4
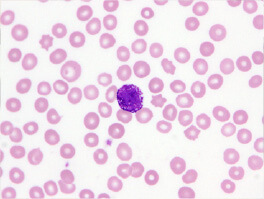
形態的検査4

血液検査室
血液検査室のご紹介
血液算定検査
血液算定検査とは血液中の成分を調べる基本的な検査です。自動分析装置を用いて血液中の細胞の数などを測定しており、炎症反応の有無、貧血や出血傾向などを調べることができます。血液算定検査では、主に以下の成分を測定します。
●赤血球
血液中で酸素を運ぶ役割を持つ細胞です。赤血球の数が少ないと貧血の可能性があり、逆に多すぎると多血症の可能性があります。
●白血球
免疫系の一部として、体を細菌やウイルスから守る役割を持つ細胞。白血球の数が多いと感染症や炎症が疑われ、少ないと免疫力が低下している可能性があります。
●血小板
血液が固まるのを助ける役割を持つ細胞です。出血した際に血栓を作って傷口を塞ぎます。血小板の数が少ないと出血しやすくなり、逆に多いと血栓ができやすくなることがあります。
●ヘモグロビン
赤血球の中に含まれる、酸素を運ぶ重要な物質です。ヘモグロビンの濃度が低いと貧血が疑われます。

形態学的検査
形態学的検査とは血液中の赤血球・白血球・血小板の細胞形態を顕微鏡で観察する検査です。自動分析器による測定値で異常が認められた場合、血液をガラスに塗沫した標本を作成、染色して顕微鏡で血液細胞の形態を観察・分類を行います。実際の顕微鏡下では以下のような細胞が認められます。


●好中球
細菌や真菌などの異物が体内に侵入した際に、最初に反応して防御する細胞です。好中球は感染が起こると、血管を通って感染部位に移動し、病原体を取り込み消化することで感染症を防ぎます。
●リンパ球
ウイルス感染やがん細胞に対する免疫に重要な細胞です。リンパ球は大きく分けて3種類あり、T細胞(感染細胞やがん細胞を直接攻撃して破壊したり、免疫反応をコントロールしたりする)、B細胞(体内に侵入した病原体に対して特定の抗体を作り病原体を無毒化する)、NK細胞(異常細胞やウイルス感染細胞を発見し、早期に排除する)などがありウイルスや異常細胞に対して特異的な免疫反応を起こします。
●単球
血液中を巡回し、細菌を取り込み消化したり免疫反応をコントロールしたりします。血液中から組織に移動するとマクロファージという細胞に変化し、異物やや死んだ細胞を取り除くために働きます。
●好酸球
寄生虫感染やアレルギー反応に関与する細胞です。例えば、花粉症や喘息などで、アレルゲン(花粉やダニなど)に反応して、体内で炎症を引き起こす物質を分泌します。この反応が過剰になるとアレルギー症状が起こります。

●好塩基球
アレルギー反応や炎症に関与する細胞です。ヒスタミンと呼ばれる物質を分泌し血管拡張を引き起こすことでアレルギー症状を助長します。
骨髄検査
血液を観察した際に異常な細胞(白血病細胞)がでていたり、その他の検査で血液疾患を疑う場合では、骨髄検査を行います。骨髄検査とは、局所麻酔下で骨(腸骨もしくは胸骨)に針を刺し骨髄液を採取する検査です。骨髄は血液細胞を作る工場のような場所であり、ここを検査することで血液疾患の診断はもちろんですが、そのほかにも癌や感染症の診断であったり、治療効果の判定を行うことができます。

フローサイトメトリ検査
フローサイトメトリ検査とは、血液やその他液体(髄液、胸水、腹水、リンパ節浮遊液など)中に含まれる細胞の特性を調べるための検査です。この検査ではそれぞれの細胞の大きさや形、細胞表面や内部に発現している抗原をフローサイトメータという機械で測定していきます。異常な細胞は正常細胞と異なる特徴を持つことが多いため、白血病やリンパ腫など血液の癌を診断するのに有用です。この他にも、移植後患者さんに対して免疫の状態を評価するために用います。

